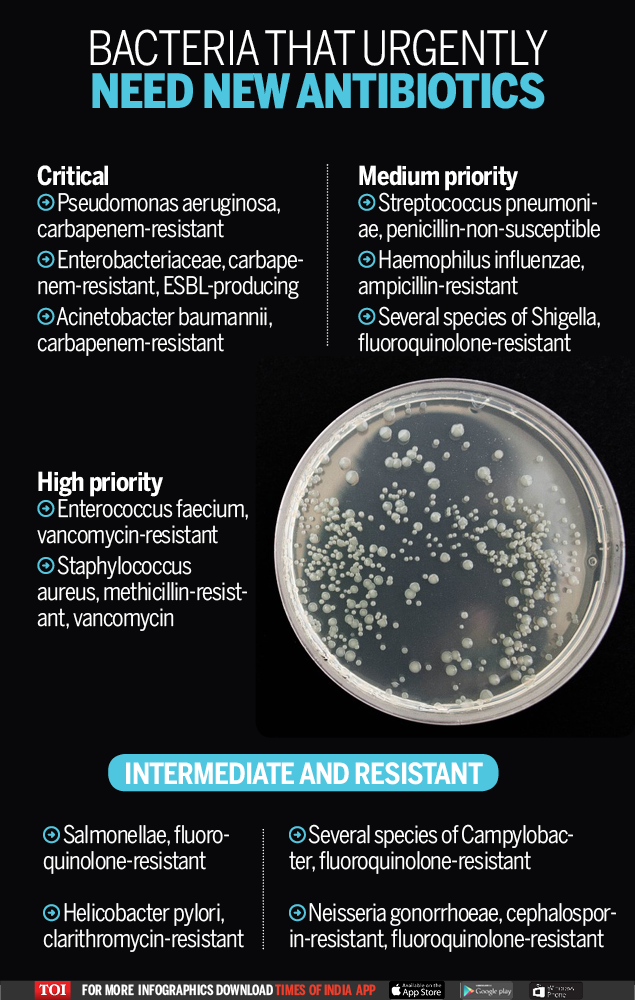

The World Health Organisation(WHO) for the first time has published a list of antibiotic-resistant 'priority pathogens' - a catalogue of 12 families of Bacteria that pose the greatest threat to human health.

The list, which was released on Monday Feb 27,2017, highlights the urgent need to adress the alarming rise in antibiotic resistance in the world.
The list, which culminates in particular the threat of gram-negative bacteria that are resistant to multiple antibiotics, is a bad news for India as most of these12 dangerous superbugs have existence in the country.
As part of WHO’s efforts to address growing global resistance to antimicrobial medicines, the list was drawn up in a bid to guide and promote research and development (R&D) of new antibiotics.
"This list is a new tool to ensure R&D responds to urgent public health needs," says Dr Marie-Paule Kieny, WHO's Assistant Director-General for Health Systems and Innovation. "Antibiotic resistance is growing, and we are fast running out of treatment options. If we leave it to market forces alone, the new antibiotics we most urgently need are not going to be developed in time."
According to the urgency of need for new antibiotics, the WHO list is divided into three categories - critical, high and medium priority.
Critical
Three bacteria were listed as critical - They include -
- Acinetobacter baumannii, carbapenem-resistant
- Pseudomonas aeruginosa, carbapenem-resistant
- Enterobacteriaceae, carbapenem-resistant, ESBL-producing
They can cause severe and often deadly infections such as bloodstream infections and pneumonia. These bacteria have become resistant to a large number of antibiotics, including carbapenems and third generation cephalosporins - the best available antibiotics for treating multi-drug resistant bacteria.
High priority
Six others were listed as high priority for new antibiotics. These are a bunch of multidrug-resistant microbes namely -
- Enterococcus faecium, vancomycin-resistant
- Staphylococcus aureus, methicillin-resistant, vancomycin-intermediate and resistant
- Helicobacter pylori, clarithromycin-resistant
- Campylobacter spp., fluoroquinolone-resistant
- Salmonellae, fluoroquinolone-resistant
- Neisseria gonorrhoeae, cephalosporin-resistant, fluoroquinolone-resistant
Medium
This category includes three other bacteria that are becoming increasingly resistant to available drugs. They are:
- Streptococcus pneumoniae, penicillin-non-susceptible
- Haemophilus influenzae, ampicillin-resistant
- Shigella spp., fluoroquinolone-resistant
Tuberculosis - whose resistance to traditional treatment has been growing in recent years - was not included in the WHO's list because it is targeted by other, dedicated programmes.
The list is intended to spur governments to put in place policies that incentivize basic science and advanced R&D by both publicly funded agencies and the private sector investing in new antibiotic discovery.
While more R&D is vital, alone, it cannot solve the problem. WHO suggests that there must also be better prevention of infections and appropriate use of existing antibiotics, as well as rational use of any new antibiotics that are developed in future to address the resistance.
No comments:
Post a Comment